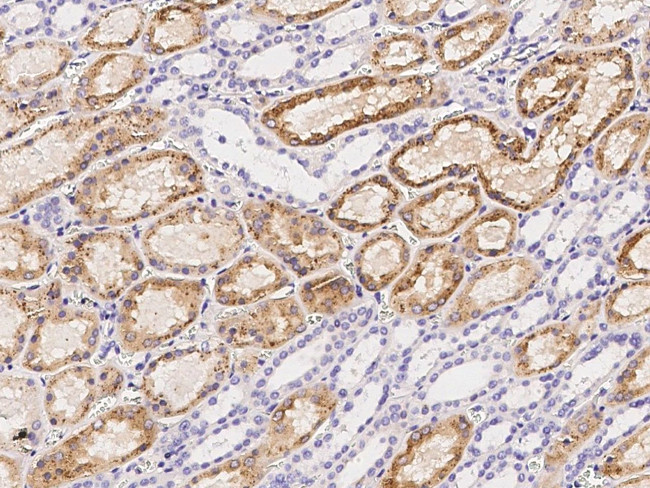
Cathepsin B Antibody in Immunohistochemistry (Paraffin) (IHC (P))

Search
Invitrogen
Cathepsin B Polyclonal Antibody
{{$productOrderCtrl.translations['antibody.pdp.commerceCard.promotion.promotions']}}
{{$productOrderCtrl.translations['antibody.pdp.commerceCard.promotion.viewpromo']}}
{{$productOrderCtrl.translations['antibody.pdp.commerceCard.promotion.promocode']}}: {{promo.promoCode}} {{promo.promoTitle}} {{promo.promoDescription}}. {{$productOrderCtrl.translations['antibody.pdp.commerceCard.promotion.learnmore']}}




Please note: We are reviewing Western blot images included in the antibody testing data in our catalog, including those provided by third parties. Unless expressly labeled or annotated as “raw-unedited”, Western blot images included in the antibody testing data in our catalog may have been edited, optimized or otherwise adjusted for presentation.
产品信息
PA5-80517
种属反应
宿主/亚型
分类
类型
抗原
偶联物
形式
浓度
规格
纯化类型
保存液
内含物
保存条件
运输条件
RRID
产品详细信息
This product is preservative free. It is recommended to add sodium azide to avoid contamination (final concentration 0.05%-0.1%).
This antibody has specificity for Human Cathepsin B/CTSB.
靶标信息
Cathepsin B is a gene located on chromosome 8p23.1 that encodes a lysosomal cysteine protease involved in intracellular protein degradation. As a member of the cathepsin family, Cathepsin B plays a crucial role in the lysosomal pathway, facilitating the breakdown of proteins into amino acids, which can then be recycled for cellular functions. In addition to its proteolytic activity within lysosomes, Cathepsin B is also implicated in extracellular matrix remodeling, cellular invasion, and apoptotic pathways. Its expression and activity are often upregulated in various cancer types, including breast, colon, and pancreatic cancers, where it contributes to tumor progression and metastasis by degrading extracellular matrix components and promoting tumor cell invasion. Due to these roles, Cathepsin B is considered a potential biomarker for cancer prognosis and a target for therapeutic intervention aimed at inhibiting cancer cell dissemination. Research continues to explore its broader implications in diseases related to protease activity and inflammation.
仅用于科研。不用于诊断过程。未经明确授权不得转售。